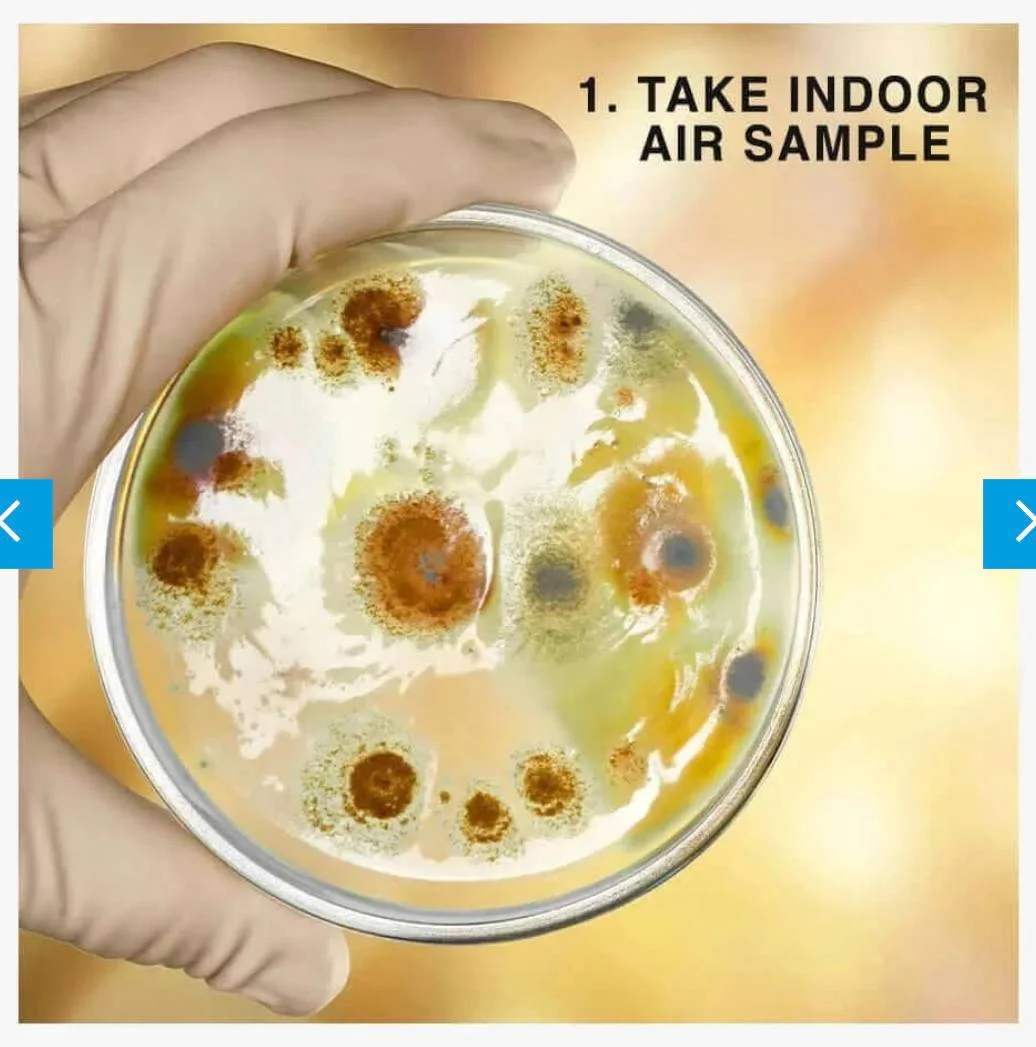

Channels / КИПР 🇨🇾 БАРАХОЛКА
КИПР 🇨🇾 БАРАХОЛКА
@baraholka_kipr · supergroup
Jaguar F-Type 2,0L 2019
Power: 300
Gearbox: Automatic
Seats: 2
MOT till: Not applicable
Body type: Coupe
Condition: Used
Extras: Alloy wheels, Cruise control, Keyless start, Rear view camera, Start/stop, Sunroof, Heated seats and more.
Year: 2019
Mileage (in km): 30000
Drive: Rear (RWD)
Engine size: 2,0L
Colour: Grey
Doors: 2 doors - 3 doors
Fuel type: Petrol
Excellent quality F-Type.
Phone number: +35799341044 (Michael)
Limassol
Price: €50.000
Power: 300
Gearbox: Automatic
Seats: 2
MOT till: Not applicable
Body type: Coupe
Condition: Used
Extras: Alloy wheels, Cruise control, Keyless start, Rear view camera, Start/stop, Sunroof, Heated seats and more.
Year: 2019
Mileage (in km): 30000
Drive: Rear (RWD)
Engine size: 2,0L
Colour: Grey
Doors: 2 doors - 3 doors
Fuel type: Petrol
Excellent quality F-Type.
Phone number: +35799341044 (Michael)
Limassol
Price: €50.000
Футболка H&M (xs) и шорты OYSHO (s)
3€
📍Пафос, Empa
📍Лимассол рядом с the Oval по вт и чт
3€
📍Пафос, Empa
📍Лимассол рядом с the Oval по вт и чт
Ice Cream Maker 🍦 идеальное состояние, был в использовании 1 раз
30€
Ларнака
30€
Ларнака
Бутылочка, ниблер, щётки, прорезыватель
10 € за всё
Лимассол, Никосия
10 € за всё
Лимассол, Никосия
Кроссовки/кеды Anta, 38 р-р 30 евро. Неаполис, Лимассол. Возле овала можно забрать в будни в обед
Сумка «TripMachine»
100% кожа, черная, ручная работа.
Новая, с бирками и коробкой.
Для тех, кто ценит качество и классику.
Размеры:
40*27*13 см в закрытом виде (40*40*13 - в открытом).
Подходит для:
путешествий (идеальный размер для ручной клади WIZZ, Ryanair и т. п.)
повседневного использования (есть отделение для бережной перевозки ноутбука)
для мотоцикла (легко устанавливается на любой мотоцикл с задней рамой).
В комплекте:
Сумка + пыльник + кожаный плечевой ремень + крутой дождевик.
Сумка отлично подойдёт для подарка активному человеку, путешественнику или мотоциклисту. Сохранилась коробка.
Стоила около 240€ + доставка
✅ отдам за 195€
Лимассол / Пафос
100% кожа, черная, ручная работа.
Новая, с бирками и коробкой.
Для тех, кто ценит качество и классику.
Размеры:
40*27*13 см в закрытом виде (40*40*13 - в открытом).
Подходит для:
путешествий (идеальный размер для ручной клади WIZZ, Ryanair и т. п.)
повседневного использования (есть отделение для бережной перевозки ноутбука)
для мотоцикла (легко устанавливается на любой мотоцикл с задней рамой).
В комплекте:
Сумка + пыльник + кожаный плечевой ремень + крутой дождевик.
Сумка отлично подойдёт для подарка активному человеку, путешественнику или мотоциклисту. Сохранилась коробка.
Стоила около 240€ + доставка
✅ отдам за 195€
Лимассол / Пафос
Тест на плесень
IVARIO Mould DIY Rapid Test
Новый, в упаковке
Привезен из Германии.
Для тех, кто давно хотел проверить присутствие плесени в воздухе у себя дома. Очень простой тест с инструкцией.
Мы сделали, результаты впечатляют.
Остался один лишний.
Рекомендуем всем хоть раз проверить состояние воздуха в своем доме, особенно, если у вас есть дети.
Отдадим за 37€ (стоил около 46€)
Лимассол / Пафос
IVARIO Mould DIY Rapid Test
Новый, в упаковке
Привезен из Германии.
Для тех, кто давно хотел проверить присутствие плесени в воздухе у себя дома. Очень простой тест с инструкцией.
Мы сделали, результаты впечатляют.
Остался один лишний.
Рекомендуем всем хоть раз проверить состояние воздуха в своем доме, особенно, если у вас есть дети.
Отдадим за 37€ (стоил около 46€)
Лимассол / Пафос
Пылесос золы для камина / мангала:
Power ash cleaner plus x300
Гениальная вещь для тех, у кого есть камин или мангал! Это намного удобнее, чем влажная уборка.
В отличии от бытового пылесоса, выдерживает температуру до 60 градусов (им можно убирать золу сразу после использования мангала/камина).
В хорошем состоянии, в использовании несколько раз.
Отдадим за 27€ (стоил около 60€)
Power ash cleaner plus x300
Гениальная вещь для тех, у кого есть камин или мангал! Это намного удобнее, чем влажная уборка.
В отличии от бытового пылесоса, выдерживает температуру до 60 градусов (им можно убирать золу сразу после использования мангала/камина).
В хорошем состоянии, в использовании несколько раз.
Отдадим за 27€ (стоил около 60€)
Киндер сюрпризы (старые- ретро)
Старая коллекция ( львята, бегемоты, крокодилы, черепахи, лягушки и т.д)
Более 100 штук.
Продажа от 10 шт разом
3 евро 1 шт.
Старая коллекция ( львята, бегемоты, крокодилы, черепахи, лягушки и т.д)
Более 100 штук.
Продажа от 10 шт разом
3 евро 1 шт.
Продаётся BMW 3 серии 318i (E36) 1994. Механическая коробка передач. Пробег: 154 тыс. Салон алькантара и кожа. Шумоизоляция, кондиционер, стеклоподъемники (передние).
Цена:3500€
Телефон для связи: 96 384336 Никос
Цена:3500€
Телефон для связи: 96 384336 Никос
Компактное рабочее место для тех квартир, где нет возможности поставить полноценный рабочий стол :)
Очень удобный стул Steelcase со столиком на колесах
Покупала на Кипре за 400 евро, отдам за 300
Очень удобный стул Steelcase со столиком на колесах
Покупала на Кипре за 400 евро, отдам за 300
Продаю Ошейники для собак убивает и отпугивает блох и клещей на 8 месяцев 25евро/Sell Collar for dogs kills and repels fleas and ticks for 8 months 25 euros
Лимассол, Гермасойя, за любой горький шоколад или килограмм любых фруктов
Книга «Идеальный Че» написанная на основе разговора автора с Хабенским, философская повесть, 18+ 🙈
Для любителей саркастических рассказов 🔥
Возможен обмен на Детское: на мальчика 0-9 мес , вещи для беременных, растения 🌱
Книга «Идеальный Че» написанная на основе разговора автора с Хабенским, философская повесть, 18+ 🙈
Для любителей саркастических рассказов 🔥
Возможен обмен на Детское: на мальчика 0-9 мес , вещи для беременных, растения 🌱
Куплю или приму в дар такое приспособление для приучения кошек к унитазу🙏🏻
если найдем - разрешат оставить моего любимого котенка)
если найдем - разрешат оставить моего любимого котенка)
Продам два горшочка для бонсай/кактусов/суккулентов. Новые стоили 30 евро каждый. Отдам за 10 штука или 15 за оба. Лимассол
Рабочие тетради по окружающему миру и литературе за 2 класс. 2€/шт. Никосия
Ноутбук Dell XPS 15 7590
OLED-дисплей 15.6" 4K разрешение
SSD M2 1ТБ
nVidia GeForce GTX 1650 4096 Мб
16 ГБ оперативная память
Intel Core i7 - 9750H 2.6 - 4.5 ГГц
Официальный Windows 11 Pro
Клавиатура - Ру/Eng
В очень хорошем состоянии, нет ни одного битого пикселя
В подарок - оригинальная сумка
750 Евро
Никосия, Строволос (но могу подъехать и в другие города)
OLED-дисплей 15.6" 4K разрешение
SSD M2 1ТБ
nVidia GeForce GTX 1650 4096 Мб
16 ГБ оперативная память
Intel Core i7 - 9750H 2.6 - 4.5 ГГц
Официальный Windows 11 Pro
Клавиатура - Ру/Eng
В очень хорошем состоянии, нет ни одного битого пикселя
В подарок - оригинальная сумка
750 Евро
Никосия, Строволос (но могу подъехать и в другие города)
Детские джинсы зара,на 11/12лет куплены в Брюсселе ,новые .20 евро Гирне
продам корзину для хранения
большая
15 евро
Лимассол,самовывоз Неаполис
большая
15 евро
Лимассол,самовывоз Неаполис
продам бокалы для вина
три бокала для красного
два бокала для белого
5 бокалов
20 евро за все
Лимассол,самовывоз Неаполис
три бокала для красного
два бокала для белого
5 бокалов
20 евро за все
Лимассол,самовывоз Неаполис
продам мини пылесос
в комплекте сам пылесос + зарядка все рабочее
пылесос можно использовать и на воду
35 евро
Лимассол,самовывоз Неаполис
в комплекте сам пылесос + зарядка все рабочее
пылесос можно использовать и на воду
35 евро
Лимассол,самовывоз Неаполис
Пафос!
Продам зеркало Икеа в идеальном состоянии, покупалось новым меньше полугода назад.
75 евро
В пределах Пафоса можем помочь с транспортировкой.
https://www.ikea.com.cy/en/products/wall-decoration-mirrors/mirrors/floor-mirrors/ikornnes-standing-mirror-52x167-cm/30298396
Продам зеркало Икеа в идеальном состоянии, покупалось новым меньше полугода назад.
75 евро
В пределах Пафоса можем помочь с транспортировкой.
https://www.ikea.com.cy/en/products/wall-decoration-mirrors/mirrors/floor-mirrors/ikornnes-standing-mirror-52x167-cm/30298396
Пафос!
Пластиковые кресла Икеа (2шт), в идеальном состоянии.
Каждое по 30 евро.
В пределах Пафоса можем помочь с транспортировкой.
https://www.ikea.com.cy/en/products/garden-outdoor/garden-chairs-benches-loungers/sun-loungers-hammocks/skarpo-armchair-outdoor/20522744
Пластиковые кресла Икеа (2шт), в идеальном состоянии.
Каждое по 30 евро.
В пределах Пафоса можем помочь с транспортировкой.
https://www.ikea.com.cy/en/products/garden-outdoor/garden-chairs-benches-loungers/sun-loungers-hammocks/skarpo-armchair-outdoor/20522744
New cases for iphone 14 , 14 pro and 14 pro max in different colors!!
Natallia Kryzhanouskaya
2023-08-16 18:13 UTC
Продаю наборы для сервировки стола: рушник, салфетки под тарелки
Ручная работа моей бабушки, за ткацким станком 18 века)
Уникальные комплекты, состав: лён и хлопок, акриловые нитки
Есть наборы, есть отдельные единицы
Отличный подарок для ваших мам, бабушек, свекровей, учителей)
Стоимость наборов от 50 евро
Салфетки от 4 евро
Рушники/дорожки от 10 евро
Ссылку на Инстаграм вышлю по запросу)
Ручная работа моей бабушки, за ткацким станком 18 века)
Уникальные комплекты, состав: лён и хлопок, акриловые нитки
Есть наборы, есть отдельные единицы
Отличный подарок для ваших мам, бабушек, свекровей, учителей)
Стоимость наборов от 50 евро
Салфетки от 4 евро
Рушники/дорожки от 10 евро
Ссылку на Инстаграм вышлю по запросу)
User 1055927794
2023-08-16 21:33 UTC
продам xbox series s геймпад (200 евро) и playstation 4 pro 2 джойстика (220)
110 messages on this day